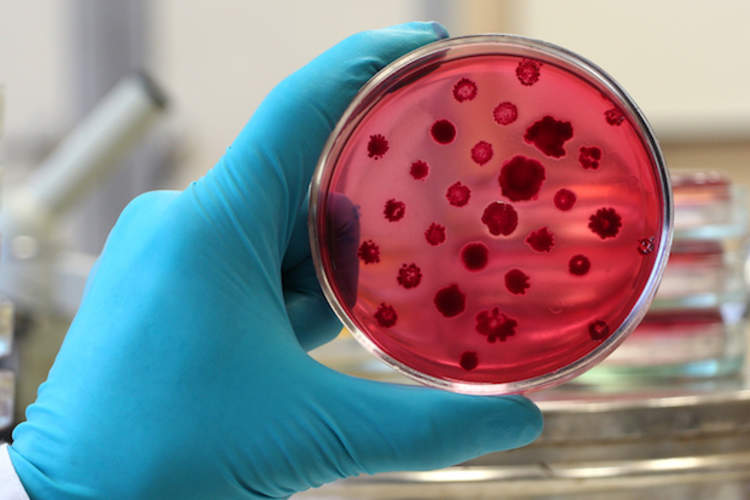
警告关于“超级病菌”

伯克利健康
最新由伯克利健康

新的建议关于前列腺癌筛查
如果你被筛选前列腺癌?这些新的准则说没有,如果你是70岁以上。

1 5位成年人感染了高危型HPV
美国成年人中,近42%的18至59感染生殖器人乳头状瘤病毒,和一个超过五个人中会有一个高风险的菌株导致癌症。

如何使你的饮食会影响您的听力
从鱼叶酸,有你的盘子上这些项目可能根据研究人员降低听力损失的风险。
新的警告关于“超级病菌”
一打抗生素耐药性“超级细菌”对人类健康构成巨大威胁,世界卫生组织警告说。

你应该避免,如果你有关节炎某些食物?
转向清晰辣椒,西红柿,茄子,土豆不会有助于预防或改善骨关节炎的症状。这里的原因。

从补充肝脏的损伤增加
许多膳食补充剂可能会损害肝脏,根据最近的审查。减肥产品,如绿茶提取物,和健美公式约占一半的病例。

女伟哥和性欲低下其他选项
女性的性反应是复杂的;许多因素,生理,心理和人际关系,都参与其中。



